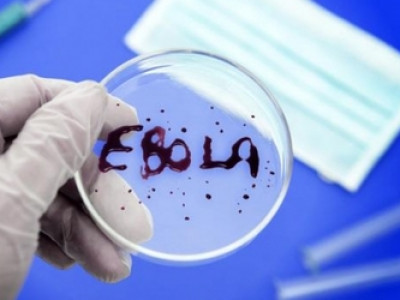
Дэлхий нийтийг түгшээсэн “Эбола” вирус

-
 Монголдоо ганц "Гэмтэл согог үндэсний төв" нь нэг хэсэг хариуцах эзэнгүй шуугиан дэгдээж байсан билээ. Энэхүү асуудал намжиж тус эмнэлэгийг захирах эзэнтэй болсон.
Тэгвэл МХЕГ-аас 2014 онд хяналт шалгалт хийхээр зарлагдсан эрсдэлтэй эмнэлгүүдэд хяналт шалгалт хийжээ. Уг шалгалтаар Гэмтэл, согог судлалын үндэсний төвийн эмч нар улсын эмнэлгийг ашиглан өөрийн хувийн дурангийн аппаратаар, гэр бүлийн гишүүний компаниас ханган нийлүүлэлтийг чанарын баталгаажилтгүйгээр, эмийн сангаар дамжуулан нийлүүлэлт хийхгүйгээр авч хиймэл үе, имплант хэрэглэдэг байсныг тогтоожээ.
Монголдоо ганц "Гэмтэл согог үндэсний төв" нь нэг хэсэг хариуцах эзэнгүй шуугиан дэгдээж байсан билээ. Энэхүү асуудал намжиж тус эмнэлэгийг захирах эзэнтэй болсон.
Тэгвэл МХЕГ-аас 2014 онд хяналт шалгалт хийхээр зарлагдсан эрсдэлтэй эмнэлгүүдэд хяналт шалгалт хийжээ. Уг шалгалтаар Гэмтэл, согог судлалын үндэсний төвийн эмч нар улсын эмнэлгийг ашиглан өөрийн хувийн дурангийн аппаратаар, гэр бүлийн гишүүний компаниас ханган нийлүүлэлтийг чанарын баталгаажилтгүйгээр, эмийн сангаар дамжуулан нийлүүлэлт хийхгүйгээр авч хиймэл үе, имплант хэрэглэдэг байсныг тогтоожээ.
2014 10 сар 09
・ 3617
-
 Мэргэжлийн хяналтын ерөнхий газраас эмнэлгүүдэд шалгалт хийжээ. Энэхүү шалгалтаар Хөвсгөл аймгийн эрүүл мэндийн газрын эмийн асуудал хариуцсан мэргэжилтэн аймгийн төвөөс алслагдсан сумдад хүчинтэй хугацаа дууссан болон дуусах дөхөж буй эм эмнэлгийн хэрэгслийг хуваарилдаг байсныг мэргэжлийн хяналтын байгууллага тогтоосон байна.
Мэргэжлийн хяналтын ерөнхий газраас эмнэлгүүдэд шалгалт хийжээ. Энэхүү шалгалтаар Хөвсгөл аймгийн эрүүл мэндийн газрын эмийн асуудал хариуцсан мэргэжилтэн аймгийн төвөөс алслагдсан сумдад хүчинтэй хугацаа дууссан болон дуусах дөхөж буй эм эмнэлгийн хэрэгслийг хуваарилдаг байсныг мэргэжлийн хяналтын байгууллага тогтоосон байна.
2014 10 сар 09
・ 3426
-
 Саяхан интернэтээр "Бүргэдийн анчин охин"-ы тухай зураг гадаадын сайтуудаар тарсан. Харин энэ нь кино зураг авалтын зураг байжээ. Гэтэл кино бүтээж буй гадаад уран бүтээлчид охинтой 1 долларын гэрээ байгуулжээ. Арай ч дээ. Энэ талаар Э.Цэрэн гэх эмэгтэй анх мэдэн энэ гэрээний талаар киноны уран бүтээлч
Саяхан интернэтээр "Бүргэдийн анчин охин"-ы тухай зураг гадаадын сайтуудаар тарсан. Харин энэ нь кино зураг авалтын зураг байжээ. Гэтэл кино бүтээж буй гадаад уран бүтээлчид охинтой 1 долларын гэрээ байгуулжээ. Арай ч дээ. Энэ талаар Э.Цэрэн гэх эмэгтэй анх мэдэн энэ гэрээний талаар киноны уран бүтээлч
2014 10 сар 08
・ 2
・ 3472
-
 уул гол нь Хан Хэнтийн нурууны салбар уулсаас эх авсан Нэргүй, Номин голын уулзвараас /Төв аймгийн Эрдэнэ сумын нутаг/ эхлэн Орхон голд цутгах хүртлээ /Сэлэнгэ аймгийн Орхонтуул сумын нутаг/ 717 км замыг туулдаг. Үүнээс 152 км нь Улаанбаатар хотоос дээш, 93 км нь Улаанбаатар хотын нутаг дэвсгэрт, 472
уул гол нь Хан Хэнтийн нурууны салбар уулсаас эх авсан Нэргүй, Номин голын уулзвараас /Төв аймгийн Эрдэнэ сумын нутаг/ эхлэн Орхон голд цутгах хүртлээ /Сэлэнгэ аймгийн Орхонтуул сумын нутаг/ 717 км замыг туулдаг. Үүнээс 152 км нь Улаанбаатар хотоос дээш, 93 км нь Улаанбаатар хотын нутаг дэвсгэрт, 472
2014 10 сар 08
・ 3710
-
 УИХ дахь МАН-ын бүлгийн Үндэсний үйлдвэрлэл, тариаланг дэмжих бүлгэмээс Ерөнхий сайдад шаардлага хүргүүллээ. Ингэхдээ гурил болон буудайг их хэмжээгээр импортоор оруулж байгаа үйл ажиллагааг яаралтай зогсоож, хариуцлагагүй шийдвэр гаргасан холбогдох албан тушаалтнуудад хариуцлага тооцохыг шаардсан байна.
УИХ дахь МАН-ын бүлгийн Үндэсний үйлдвэрлэл, тариаланг дэмжих бүлгэмээс Ерөнхий сайдад шаардлага хүргүүллээ. Ингэхдээ гурил болон буудайг их хэмжээгээр импортоор оруулж байгаа үйл ажиллагааг яаралтай зогсоож, хариуцлагагүй шийдвэр гаргасан холбогдох албан тушаалтнуудад хариуцлага тооцохыг шаардсан байна.
2014 10 сар 08
・ 3438
-
 Япон, БНХАУ, Шинэ Зеланд, БНСУ-ын экспертүүдээс бүрдсэн үнэлгээний баг Монгол Улсад 10 дугаар сарын 06-наас 10 ны өдрүүдэд ажиллаж байна. Олон улсын үнэлгээний баг Нийслэлийн Онцгой байдлын газар, Аврах тусгай ангийн үйл ажиллагаа, Сэлэнгэ аймагт ажиллаж Монгол Улсын гамшгаас хамгаалах бүтэц, үйл ажиллагаа, албан хаагчдын бэлтгэл бэлэн байдал, эрэн хайх, аврах ажиллагааны өнөөгийн чадавхи, багаж техник хэрэгсэлтэй танилцаад, дүн шинжилгээ хийж, зөвлөмж гаргах юм.
Япон, БНХАУ, Шинэ Зеланд, БНСУ-ын экспертүүдээс бүрдсэн үнэлгээний баг Монгол Улсад 10 дугаар сарын 06-наас 10 ны өдрүүдэд ажиллаж байна. Олон улсын үнэлгээний баг Нийслэлийн Онцгой байдлын газар, Аврах тусгай ангийн үйл ажиллагаа, Сэлэнгэ аймагт ажиллаж Монгол Улсын гамшгаас хамгаалах бүтэц, үйл ажиллагаа, албан хаагчдын бэлтгэл бэлэн байдал, эрэн хайх, аврах ажиллагааны өнөөгийн чадавхи, багаж техник хэрэгсэлтэй танилцаад, дүн шинжилгээ хийж, зөвлөмж гаргах юм.
2014 10 сар 08
・ 3346
-
 Гадаадад сурч, ажиллаж байгаа, эх орноо гэсэн халуун сэтгэлтэй олон мянган монголчууд олон нийтийн сүлжээ болох фэйсбүүкээр нэгдэн, Монгол Улсын тусгаар тогтнол, аюулгүй байдлын талаарх саналаа Газрын болон бусад хуулиудтай холбогдуулан илэрхийлж, өнгөрөгч зуны наадмаар гарын үсэг цуглуулжээ.
Гадаадад сурч, ажиллаж байгаа, эх орноо гэсэн халуун сэтгэлтэй олон мянган монголчууд олон нийтийн сүлжээ болох фэйсбүүкээр нэгдэн, Монгол Улсын тусгаар тогтнол, аюулгүй байдлын талаарх саналаа Газрын болон бусад хуулиудтай холбогдуулан илэрхийлж, өнгөрөгч зуны наадмаар гарын үсэг цуглуулжээ.
2014 10 сар 08
・ 3365
-
 Монголын Залуучуудын Холбоо “Спирт үү, спорт уу” аяныхаа хүрээнд “Унадаг дугуйтай Улаанбаатар” төслийг хэрэгжүүлж эхэлсэн бөгөөд залуучуудын дунд давалгаалж байгаа хамгийн үр дүнтэй төсөл болж байгаа гэдэгтэй хэн ч маргахгүй байх аа.
Монголын Залуучуудын Холбоо “Спирт үү, спорт уу” аяныхаа хүрээнд “Унадаг дугуйтай Улаанбаатар” төслийг хэрэгжүүлж эхэлсэн бөгөөд залуучуудын дунд давалгаалж байгаа хамгийн үр дүнтэй төсөл болж байгаа гэдэгтэй хэн ч маргахгүй байх аа.
2014 10 сар 08
・ 3405
-
 Монголын хөрөнгийн биржийн энэ сарын 08-ны өдрийн үнэт цаасны арилжаагаар 13 хувьцаат компанийн нийт 15,535 ширхэг хувьцаа арилжигдаж, 23,963,670.00 төгрөгийн гүйлгээ хийгджээ.
Монголын хөрөнгийн биржийн энэ сарын 08-ны өдрийн үнэт цаасны арилжаагаар 13 хувьцаат компанийн нийт 15,535 ширхэг хувьцаа арилжигдаж, 23,963,670.00 төгрөгийн гүйлгээ хийгджээ.
2014 10 сар 08
・ 3298
-
 Эбола вириус дэгдсэн цагаасаа хойш Африк тивийн түүхэнд байгаагүй хохирол учруулж газар авчсаар байна. Уг вирусын халдварын дэгдэлт сүүлийн үед дэлхийн хэд хэдэн оронд гарч, үргэлжилсээр олны анхаарлыг ихээхэн татаж, санаа зовоож байгаа билээ. Вирусаар өвчилсөн хүмүүсийг хүн төрөлхтөнд эмчилж чадахгүй байгаагаас 90 хүртэлх хувь нь амиа алдаж байгаа юм.
Эбола вириус дэгдсэн цагаасаа хойш Африк тивийн түүхэнд байгаагүй хохирол учруулж газар авчсаар байна. Уг вирусын халдварын дэгдэлт сүүлийн үед дэлхийн хэд хэдэн оронд гарч, үргэлжилсээр олны анхаарлыг ихээхэн татаж, санаа зовоож байгаа билээ. Вирусаар өвчилсөн хүмүүсийг хүн төрөлхтөнд эмчилж чадахгүй байгаагаас 90 хүртэлх хувь нь амиа алдаж байгаа юм.
2014 10 сар 08
・ 3412
-
 Хэдхэн хоногийн өмнө БНСУ-ын Инчён хотод болсон Азийн спортын 17 дугаар наадмын жүдо бөхийн барилдааны үеэр манай эмэгтэй баг тамирчдын идэж байсан хоолноос хэрэглэсэн ариун цэврийн хэрэгсэл илэрч, хэвлэлээр шуугиан тарьсан. Энэ талаар Монголын жүдо бөхийн холбооны дэд ерөнхийлөгч М.Бөхбат анх удаа хэвлэлийнхэнд бодит мэдээллийг өглөө.
Хэдхэн хоногийн өмнө БНСУ-ын Инчён хотод болсон Азийн спортын 17 дугаар наадмын жүдо бөхийн барилдааны үеэр манай эмэгтэй баг тамирчдын идэж байсан хоолноос хэрэглэсэн ариун цэврийн хэрэгсэл илэрч, хэвлэлээр шуугиан тарьсан. Энэ талаар Монголын жүдо бөхийн холбооны дэд ерөнхийлөгч М.Бөхбат анх удаа хэвлэлийнхэнд бодит мэдээллийг өглөө.
2014 10 сар 08
・ 3
・ 3834
-
 Интернетед утаа нь уугиж, Ийглээр гал нь дүрэлзсэн 500 сая долларын өртөгтэй түймэр. Хамгийн сүүлийн үеийн Монголын дэлхийд цацагдсан сенсаац гэвэл сургуулийн хүүхдээс авахуулаад сүмийн пастор хүртэл шагшин ярьж байгаа Шангрилагийн түймэр юм.
Интернетед утаа нь уугиж, Ийглээр гал нь дүрэлзсэн 500 сая долларын өртөгтэй түймэр. Хамгийн сүүлийн үеийн Монголын дэлхийд цацагдсан сенсаац гэвэл сургуулийн хүүхдээс авахуулаад сүмийн пастор хүртэл шагшин ярьж байгаа Шангрилагийн түймэр юм.
2014 10 сар 08
・ 4
・ 3847
-
 Борлуулагч залууг дэлгүүрийн эзэн П гэгч хөнөөснөө хүлээлээ
Борлуулагч залууг дэлгүүрийн эзэн П гэгч хөнөөснөө хүлээлээ
2014 10 сар 07
・ 7
・ 4152
-
 Ховд аймгийн Булган суманд ажил үүргээ гүйцэтгэж явсан цагдаагийн дэд ахлагч Б.Төмөрчөдөрийн амь насыг хөнөөсөн хэрэг өнгөрсөн дөрөвдүгээр сард гарсан.
Ховд аймгийн Булган суманд ажил үүргээ гүйцэтгэж явсан цагдаагийн дэд ахлагч Б.Төмөрчөдөрийн амь насыг хөнөөсөн хэрэг өнгөрсөн дөрөвдүгээр сард гарсан.
2014 10 сар 07
・ 3580
-
 Нийтийн тээврийг дагасан олон асуудал бий. Тухайлбал, "Автобус-1" компанийн Шархад- III, IV хороолол чиглэлийн 13 дугаарын автобусыг иргэд "галзуу хулгана" хэмээдэг.
Нийтийн тээврийг дагасан олон асуудал бий. Тухайлбал, "Автобус-1" компанийн Шархад- III, IV хороолол чиглэлийн 13 дугаарын автобусыг иргэд "галзуу хулгана" хэмээдэг.
2014 10 сар 07
・ 3918
-
 Монгол улсын хөгжил цэцэглэлт урагшаа нэг, хойшоо хоёр алхаж байхад зарим нэг салбар цаана чинь “гэрлийн хурдаар” хөгжөөд байна.
Монгол улсын хөгжил цэцэглэлт урагшаа нэг, хойшоо хоёр алхаж байхад зарим нэг салбар цаана чинь “гэрлийн хурдаар” хөгжөөд байна.
2014 10 сар 07
・ 3781
-
 Сүүлийн хэдэн сар ССАЖ-ын сайд Ц.Оюунгэрэл рүү боорлогчдын фронт өргөн бүрэлдэхүүнтэй болж өдгөө Засгаас гаргах сайд нарын жагсаалтад автоматаар оруулчихлаа. Энэ нь, ингэх нь цаанаа учиртай.
Сүүлийн хэдэн сар ССАЖ-ын сайд Ц.Оюунгэрэл рүү боорлогчдын фронт өргөн бүрэлдэхүүнтэй болж өдгөө Засгаас гаргах сайд нарын жагсаалтад автоматаар оруулчихлаа. Энэ нь, ингэх нь цаанаа учиртай.
2014 10 сар 07
・ 3376
-
 Мансууруулах, сэтгэцэд нөлөөлөх үйлчилгээтэй каннабис гэх ургамлыг түүж, худалдаалдаг бүлэг этгээдүүдийг Цагдаагийн ерөнхий газрын Зохион байгуулалттай тэмцэх хэлтсээс баривчилжээ.
Мансууруулах, сэтгэцэд нөлөөлөх үйлчилгээтэй каннабис гэх ургамлыг түүж, худалдаалдаг бүлэг этгээдүүдийг Цагдаагийн ерөнхий газрын Зохион байгуулалттай тэмцэх хэлтсээс баривчилжээ.
2014 10 сар 07
・ 3596
-
 Ургац хураалтын ажил дуусаагүй байхад импортын будааны хэрүүл дэгдээд буй. Өнөөх “алаагүй баавгайн арьсыг хуваах”-ын үлгэр л болж байна.
Ургац хураалтын ажил дуусаагүй байхад импортын будааны хэрүүл дэгдээд буй. Өнөөх “алаагүй баавгайн арьсыг хуваах”-ын үлгэр л болж байна.
2014 10 сар 06
・ 3684
-
Одоогоос олон жилийн өмнөх явдал юмдаг. Дүү маань ЕБС-ийн бага ангийн сурагч байхдаа ангийнхан нь нэгэндээ туслах зорилгоор мөнгө хураасан гэдэг.
Одоогоос олон жилийн өмнөх явдал юмдаг. Дүү маань ЕБС-ийн бага ангийн сурагч байхдаа ангийнхан нь нэгэндээ туслах зорилгоор мөнгө хураасан гэдэг.
2014 10 сар 06
・ 3523